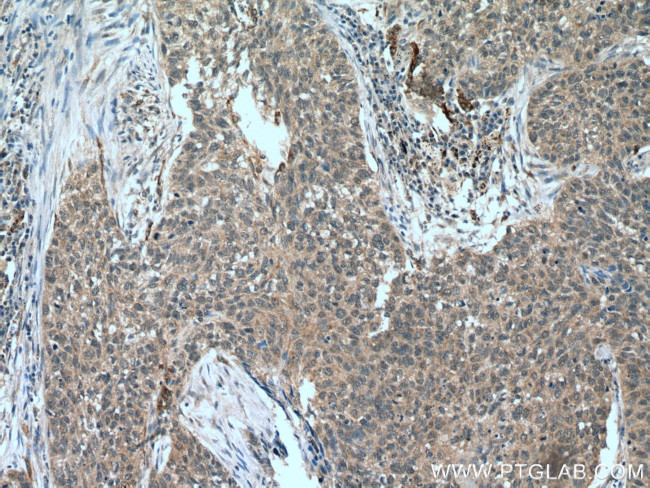
FMO2 Antibody in Immunohistochemistry (Paraffin) (IHC (P))

Search
Proteintech
FMO2 Polyclonal Antibody
{{$productOrderCtrl.translations['antibody.pdp.commerceCard.promotion.promotions']}}
{{$productOrderCtrl.translations['antibody.pdp.commerceCard.promotion.viewpromo']}}
{{$productOrderCtrl.translations['antibody.pdp.commerceCard.promotion.promocode']}}: {{promo.promoCode}} {{promo.promoTitle}} {{promo.promoDescription}}. {{$productOrderCtrl.translations['antibody.pdp.commerceCard.promotion.learnmore']}}
产品信息
15725-1-AP
种属反应
宿主/亚型
分类
类型
抗原
偶联物
形式
浓度
规格
纯化类型
保存液
内含物
保存条件
运输条件
产品详细信息
This antibody is specifically against FMO2. It does not bind other FMOs.
Immunogen sequence: EPTCFERTE DIGGVWRFKE NVEDGRASIY QSVVTNTSKE MSCFSDFPMP EDFPNFLHNS KLLEYFRIFA KKFDLLKYIQ FQTTVLSVRK CPDFSSSGQW KVVTQSNGKE QSAVFDAVMV CSGHHILPHI PLKSFPGMER FKGQYFHSRQ YKHPDGFEGK RILVIGMGNS GSDIAVELSK NAAQVFISTR HGTWVMSRIS EDGYPWDSVF HTRFRSMLRN VLPRTAVKWM IEQQMNRWFN HENYGLEPQN KYIMKEPVLN DDVPSRLLCG AIKVKSTVKE LTETSAIFED GTVEENIDVI IFATGYSFSF PFLEDSLVKV ENNMVSLYKY IFPAHLDKST LACIGLIQPL GSIFPTAELQ A (27-386 aa encoded by BC005894)
靶标信息
The flavin-containing monooxygenases are NADPH-dependent enzymes that catalyze the oxidation of many drugs and xenobiotics. In most mammals, there is a flavin-containing monooxygenase that catalyzes the N-oxidation of some primary alkylamines through an N-hydroxylamine intermediate. However, in humans, this enzyme is truncated and is probably rapidly degraded. The protein encoded by this gene represents the truncated form and apparently has no catalytic activity. A functional allele found in African Americans has been reported, but no sequence evidence has been deposited to support the finding. This gene is found in a cluster with the FMO1, FMO3, and FMO4 genes on chromosome 1.
仅用于科研。不用于诊断过程。未经明确授权不得转售。
篇参考文献 (0)
生物信息学
蛋白别名: Dimethylaniline monooxygenase [N-oxide-forming] 2; Dimethylaniline oxidase 2; flavin containing monooxygenase 2 (non-functional); Flavin-containing monooxygenase 2; FMO 1B1; FMO 2; FMO, pulmonary; Pulmonary flavin-containing monooxygenase 2; unnamed protein product
基因别名: 2310008D08Rik; 2310042I22Rik; AW107733; FMO1B1; FMO2
UniProt ID: (Human) Q99518, (Mouse) Q8K2I3, (Rat) Q6IRI9
Entrez Gene ID: (Human) 2327, (Mouse) 55990, (Rat) 246245